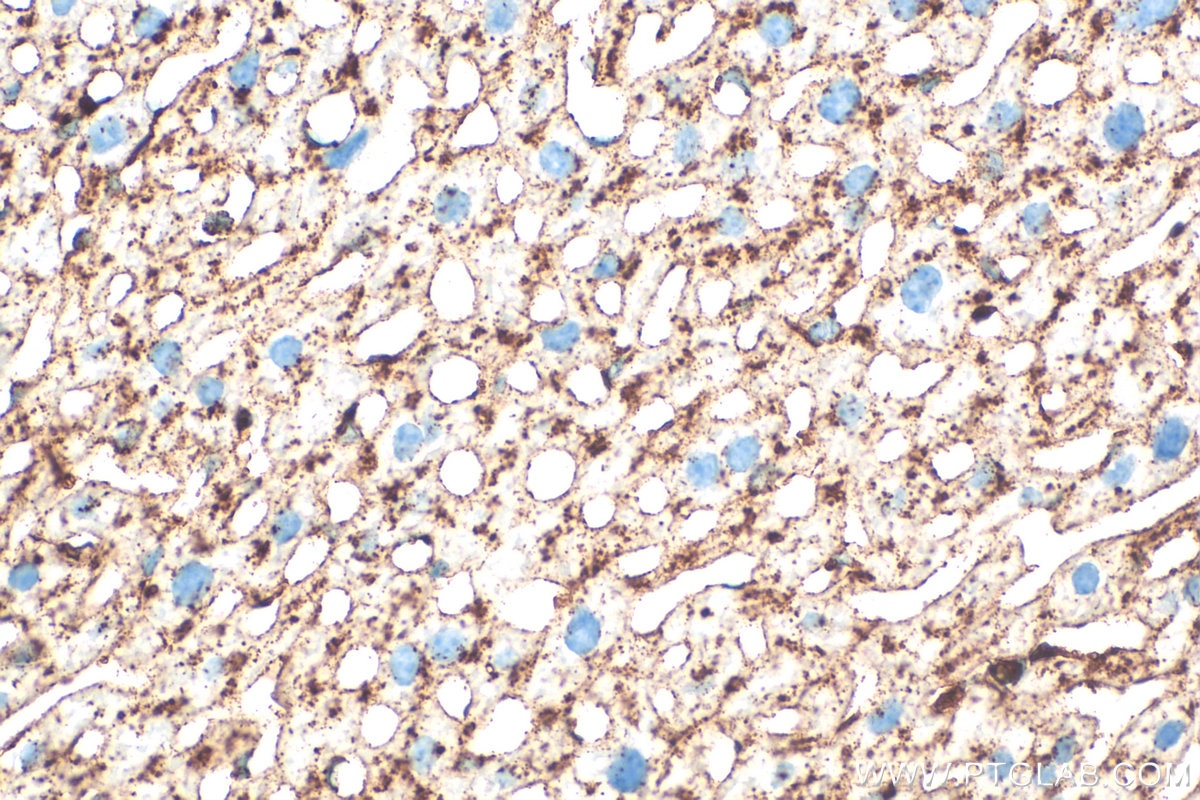
Immunohistochemical analysis of paraffin-embedded mouse liver tissue slide using 33243-1-AP (CD107a / LAMP1 antibody) at dilution of 1:1000 (under 40x lens). Heat mediated antigen retrieval with Tris-EDTA buffer (pH 9.0). Immunohistochemistry (IHC) staining of mouse liver tissue using CD107a / LAMP1 Polyclonal antibody (33243-1-AP)
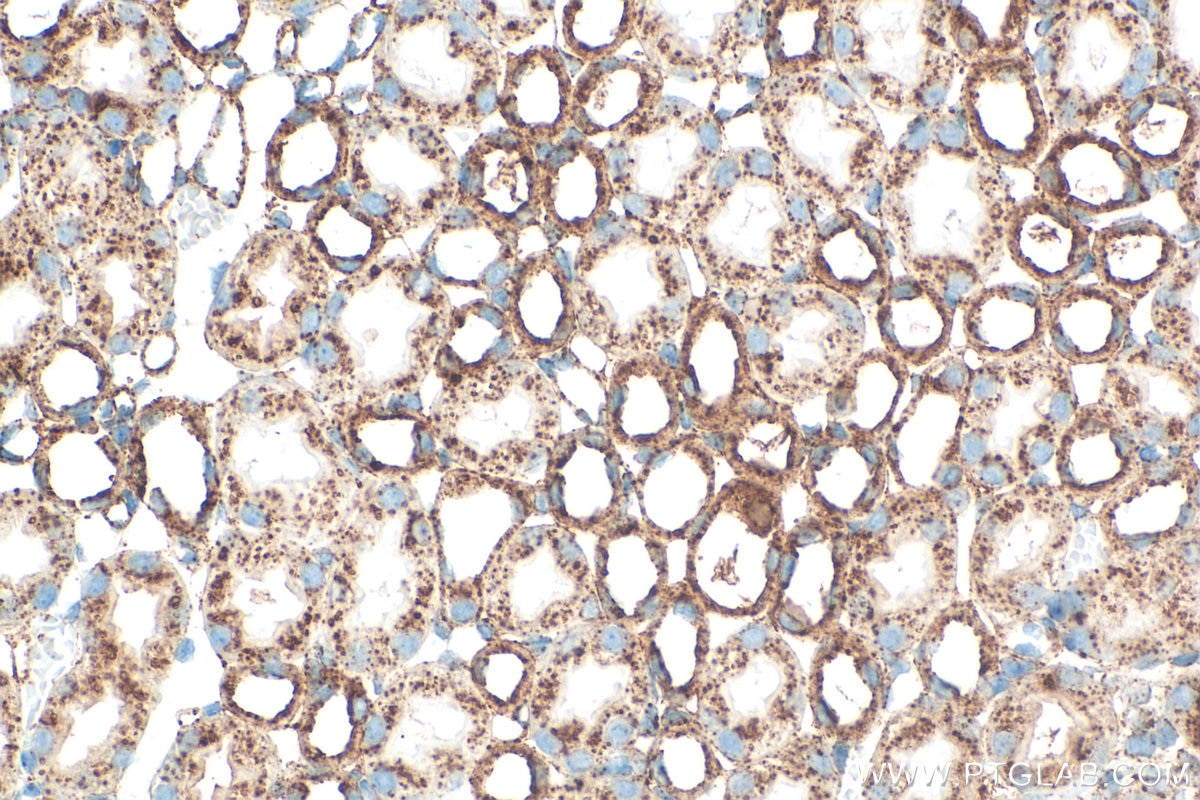
Immunohistochemical analysis of paraffin-embedded mouse kidney tissue slide using 33243-1-AP (CD107a / LAMP1 antibody) at dilution of 1:1000 (under 40x lens). Heat mediated antigen retrieval with Tris-EDTA buffer (pH 9.0). Immunohistochemistry (IHC) staining of mouse kidney tissue using CD107a / LAMP1 Polyclonal antibody (33243-1-AP)

Tested Applications
| Positive WB detected in | J774A.1 cells, NIH/3T3 cells, RAW 264.7 cells |
| Positive IHC detected in | mouse liver tissue, mouse kidney tissue Note: suggested antigen retrieval with TE buffer pH 9.0; (*) Alternatively, antigen retrieval may be performed with citrate buffer pH 6.0 |
| Positive IF/ICC detected in | NIH/3T3 cells |
Recommended dilution
| Application | Dilution |
|---|---|
| Western Blot (WB) | WB : 1:5000-1:50000 |
| Immunohistochemistry (IHC) | IHC : 1:500-1:2000 |
| Immunofluorescence (IF)/ICC | IF/ICC : 1:50-1:500 |
| It is recommended that this reagent should be titrated in each testing system to obtain optimal results. | |
| Sample-dependent, Check data in validation data gallery. | |
Product Information
33243-1-AP targets CD107a / LAMP1 in WB, IHC, IF/ICC, ELISA applications and shows reactivity with mouse samples.
| Tested Reactivity | mouse |
| Host / Isotype | Rabbit / IgG |
| Class | Polyclonal |
| Type | Antibody |
| Immunogen |
CatNo: Eg3858 Product name: Recombinant Mouse LAMP-1/CD107a protein (rFc Tag) (HPLC verified) Source: mammalian cells-derived, pHZ-KIsec-C-rFc Tag: C-rFc Domain: 25-370 aa of NM_010684.3 Sequence: LFEVKNNGTTCIMASFSASFLTTYETANGSQIVNISLPASAEVLKNGSSCGKENVSDPSLTITFGRGYLLTLNFTKNTTRYSVQHMYFTYNLSDTEHFPNAISKEIYTMDSTTDIKADINKAYRCVSDIRVYMKNVTVVLRDATIQAYLSSGNFSKEETHCTQDGPSPTTGPPSPSPPLVPTNPTVSKYNVTGNNGTCLLASMALQLNITYLKKDNKTVTRAFNISPNDTSSGSCGINLVTLKVENKNRALELQFGMNASSSLFFLQGVRLNMTLPDALVPTFSISNHSLKALQATVGNSYKCNTEEHIFVSKMLSLNVFSVQVQAFKVDSDRFGSVEECVQDGNN Predict reactive species |
| Full Name | lysosomal-associated membrane protein 1 |
| Calculated Molecular Weight | 44 kDa |
| Observed Molecular Weight | 120 kDa |
| GenBank Accession Number | NM_010684.3 |
| Gene Symbol | CD107a |
| Gene ID (NCBI) | 16783 |
| RRID | AB_3742912 |
| Conjugate | Unconjugated |
| Form | Liquid |
| Purification Method | Antigen affinity Purification |
| UNIPROT ID | P11438 |
| Storage Buffer | PBS with 0.02% sodium azide and 50% glycerol, pH 7.3. |
| Storage Conditions | Store at -20°C. Stable for one year after shipment. Aliquoting is unnecessary for -20oC storage. 20ul sizes contain 0.1% BSA. |
Background Information
LAMP1 (CD107a) is a heavily glycosylated membrane protein enriched in the lysosomal membrane. LAMP1 is extensively glycosylated with asparagine-linked oligosaccharides which protect it from intracellular proteolysis (PMID: 10521503). Although LAMP1 is expressed largely in the endosome-lysosomal membrane of cells, it is also found on the plasma membrane (PMID: 16168398). Elevated LAMP1 expression at the cell surface has also been detected during platelet and granulocytic cell activation, as well as in some tumor cells (PMID: 29085473). LAMP1 functions to provide selectins with carbohydrate ligands. This protein has also been shown to be a marker of degranulation on lymphocytes such as CD8+ and NK cells and may also play a role in tumor cell differentiation and metastasis (PMID: 18835598; 29085473; 9426697).
Protocols
| Product Specific Protocols | |
|---|---|
| IF protocol for CD107a / LAMP1 antibody 33243-1-AP | Download protocol |
| IHC protocol for CD107a / LAMP1 antibody 33243-1-AP | Download protocol |
| WB protocol for CD107a / LAMP1 antibody 33243-1-AP | Download protocol |
| Standard Protocols | |
|---|---|
| Click here to view our Standard Protocols |